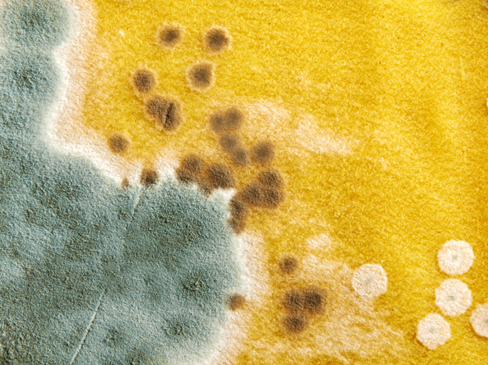
Mold-inspector-Florence-KY Inspection-for-Mold-Florence-KY

Found Mold During a Home Inspection – Now What?
A thorough inspection for mold is one of the most important steps when buying a new home. An assessment helps identify any issues or damage that affect the value and safety of the property. If you have a moisture problem, mold is one common home inspection issue.
Finding mold in a home is alarming, but it’s essential to understand what steps
to take next. This article discusses what to do if an inspector finds mold during a home inspection.
What is Mold?
Most new buyers don’t know how to handle an inspection. They aren’t sure what to expect from their inspector or what questions they should ask them. Mold is a fungus that grows in humid environments.
It can appear as black, green, or white spots and can have a musty odor. Mold grows on walls, ceilings, and floors which can spread quickly. Finding mold during a home inspection can be stressful for any homeowner.
It’s a health hazard and can lead to costly repairs and challenges with selling the home. Mold can cause respiratory issues and aggravate mold allergies.
Types of Mold in Northern Kentucky Homes
Molds propagate by producing resilient spores capable of surviving in uninhabitable conditions. Within households, mold spores are in the air as they thrive in spaces with elevated humidity levels, like bathrooms and basements. While countless molds exist, prevalent indoor species include:
• Cladosporium
• Penicillium
• Aspergillus
Stachybotrys Chartarum, known as black mold, is a toxic mold that usually develops from prolonged water leakage. Unlike molds that thrive in high humidity, this fungus needs complete water saturation and sustained moisture to flourish. While many consider black mold the most dangerous, things aren’t as they seem.
Many types of mold are toxic. Researchers refer to “black molds” as those that produce mycotoxins. These mycotoxins provoke allergic reactions and more severe side effects in susceptible individuals.
Though they have a potential for strong toxicity, there is no evidence that airborne mycotoxins cause diseases. Consuming high dosages of mycotoxins can be detrimental, leading to acute poisoning and fatalities. What we know for sure is that no mold belongs in a home.
Scenarios for Inspection for Mold
If you have the home professionally inspected, the report could indicate that mold is present. When a home inspector discovers mold, you should document its presence. Inspectors often bring attention to signs of mold, even though it’s not their direct responsibility to search for it.
Some inspectors may want to avoid liability, but they may advise you on your next steps concerning potential scenarios.
Scenario #1: Your inspector
If a home inspector finds mold during a home inspection, contact your real estate agent. Get a quote for repairs and negotiate with the home sellers. They can either remove the mold or take into consideration the cost of mold removal.
Scenario #2: The inspector
Homeowners may not realize that their houses have mold, which can affect the negotiation terms and prices. Sellers could subtract the cost of remediation from the house price.
Scenario #3: An inspector thinks they found mold but isn’t sure
If you suspect the presence of mold, it’s best to consult with a certied mold inspector. They can confirm its existence, or they may suggest you get a home mold testing kit.
Steps to Take if Mold is Found During a Home Inspection
If an inspector finds a mold problem in your home, here’s how you can address it:
1. Notify Your Realtor
First, inform your realtor of the mold’s presence. They can offer advice on repairs or remediation. If there’s no mold disclosure, your realtor can negotiate with the sellers.
2. Schedule a Mold Inspection and Testing Service
You should schedule professional mold inspection services and testing if you suspect mold in your home. A certified mold inspector will examine your home, test for mold, and assess the indoor air quality. They will also take samples to determine the type and severity of the mold infestation in your home.
After the inspection, you’ll get a detailed report of the mold growth’s extent and the recommended remediation steps.
3. Ask Your Inspector Questions
During the home inspection, ask your inspector questions about any mold they find. They can offer insight into the cause, like water leaks, and provide recommendations for preventing mold growth.
How to Handle Mold During a Home Sale
If you find mold while selling your home, handle it carefully and be honest. Here are some steps to take:
1. Get an Assessment
It’s essential to hire a professional to evaluate mold issues, just as you would if living in the home. An assessment will help with proper mold removal, making the home safe for new owners.
2. Disclose the Mold
You should disclose the mold issue to your real estate agent and any potential buyers. In most states, the law requires it, and failing to disclose could lead to legal problems. In Northern Kentucky, single-family residential sellers must make certain disclosures to potential buyers.
The law applies regardless of whether you involve a salesperson or broker. However, the disclosure form clearly states you don’t have to verify any disclosures with a formal inspection. You need only disclose defects or conditions you know about while living in the property.
You’re under no obligation to hire an inspector to find a defect you don’t have “reasonable” knowledge about. However, you must disclose the results if you do a home inspection.
3. Provide Documentation
When selling a property, provide documentation of any mold issue and the remediation steps. Documentation will give potential buyers peace of mind and show that you took care of the problem.

Final Thoughts
If you are selling your home, disclose the mold issue and provide documentation to potential buyers. Finding mold during a home inspection can be stressful, but it doesn’t mean your home sale or possible commission is gone. The best way to handle things is to take the proper steps to address the issue.
At AA Home Inspection, LLC, we’re InterNACHI-certified home inspectors specializing in mold detection. Our reliable home inspection services will identify and address common property issues. We provide mold inspection services in Northern KY and Cincinnati communities.
With experienced inspectors, we conduct thorough home inspections and provide detailed reports. We’ll inform you of any mold concerns and help you decide what to do next. Contact us today to learn more about how we can help you sell your property or buy a home with confidence.
Meta Description: If you find mold during a home inspection, take the necessary steps to address the issue. This blog discusses what to do once you find mold in the home.